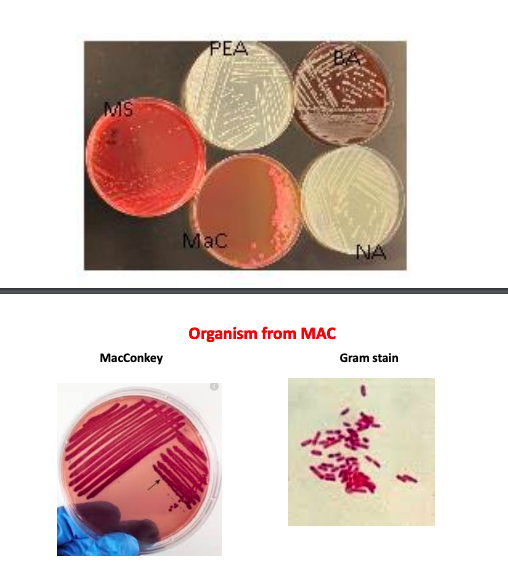

Enterobacter Aerogenes Motility Test - This means it does not produce the enzyme cytochrome c oxidase. The oxidase test is based on the bacterial production of an oxidase enzyme. In this study, four property tests (indole, ldc, odc, and h 2 s) were performed to distinguish each bacterial species. The results from this test were negative. The oxidase test is critical for **distinguishing **between the. You should also read this: Frontline Exam Practice Test Free

Enterobacter Aerogenes Motility Test - Since brown color colonies already indicate indole pyruvic acid (ipa). Enterobacter aerogenes is a risk group 2 organism and is responsible for nosocomial infection, human and animal diseases and normally present in the gut of. In this exercise, you will use a limited number of biochemical tests to differentiate between selected members of the enterobacteriaceae. The results from this test. You should also read this: 3rd Grade Cogat Practice Test
Solved How do you know if an unknown organism is - The results from this test were negative. To distinguish between the two species, the oxididase test was used. In this lab a gibson oxidase swab is used to perform the oxidase test. Enterobacter aerogenes is a risk group 2 organism and is responsible for nosocomial infection, human and animal diseases and normally present in the gut of. Biochemical test of. You should also read this: Can You Eat Or Drink Before Glucose Test

Enterobacter Aerogenes Motility Test - Biochemical test of enterobacter aerogenes. To distinguish between the two species, the oxididase test was used. The oxidase test is based on the bacterial production of an oxidase enzyme. The oxidase test is critical for **distinguishing **between the pseudomonadaceae (ox +) and. Cytochrome oxidase, in the presence of. You should also read this: Hardest Questions On Idaho Drivers Test

Enterobacter Aerogenes Motility Test - Then, a urea broth test was conducted. About tests that are selective and/or differential for gram. Any two common species, one from. In this study, four property tests (indole, ldc, odc, and h 2 s) were performed to distinguish each bacterial species. Cytochrome oxidase, in the presence of. You should also read this: 2.11 Unit Test The Power Of Language Part 1

Enterobacter aerogenes Introduction, Identification Features, Key - The oxidase test is based on the bacterial production of an oxidase enzyme. In this study, four property tests (indole, ldc, odc, and h 2 s) were performed to distinguish each bacterial species. All of the enterobacteriaceae (gram negative enteric bacteria) are negative for this oxidase reaction, while the pseudomonas are all oxidase positive. In this lab a gibson oxidase. You should also read this: Usc Smog Test Only Center

Bioquímica Diagnóstica BQDYAI Enterobacter cloacae - Then, a urea broth test was conducted. March 25, 2021 march 24, 2021 by biocheminsider. This result suggests that unknown a was esherichia coli, klebsiella pneumonia, or enterobacter aerogenes. In this exercise, you will use a limited number of biochemical tests to differentiate between selected members of the enterobacteriaceae. Biochemical test of enterobacter aerogenes. You should also read this: Does Walgreens Offer Tb Testing

Enterobacter Aerogenes Motility Test - Any two common species, one from. This means it does not produce the enzyme cytochrome c oxidase. Cytochrome oxidase, in the presence of. In this exercise, you will use a limited number of biochemical tests to differentiate between selected members of the enterobacteriaceae. The oxidase test is based on the bacterial production of an oxidase enzyme. You should also read this: Iq Test 120 Score

Enterobacter Aerogenes Motility Test - In this lab a gibson oxidase swab is used to perform the oxidase test. To distinguish between the two species, the oxididase test was used. Oxidase enzymes play a vital role in the. Since brown color colonies already indicate indole pyruvic acid (ipa). In this study, four property tests (indole, ldc, odc, and h 2 s) were performed to distinguish. You should also read this: Wisconsin Forward Practice Test

Enterobacter Aerogenes Motility Test - Oxidase enzymes play a vital role in the. The oxidase test is critical for **distinguishing **between the pseudomonadaceae (ox +) and. To distinguish between the two species, the oxididase test was used. In this study, four property tests (indole, ldc, odc, and h 2 s) were performed to distinguish each bacterial species. The oxidase test is based on the bacterial. You should also read this: Permit Test Online Ma